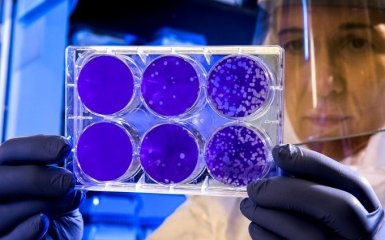
Могут ли опять усилить карантин - в Минздраве наконец-то ответили

3 июня Министерсто здоровья сообщило о новом скачке числа больных коронавирусом в Украине - сейчас уже зафиксированы 24 823 случая заражения. За последние сутки выявлено 483 новых случая. Кроме того, 735 человек скончались из-за осложненй, вызванных коронавирусной болезнью. В связи с этим украинское правительство срочно собралось для детального обсуждения усиления карантина. В результате Кабмин пришел к выводу, что решение об усилении будут принимать комиссии на местах в регионах. Эту информацию уже подтвердил глава Минздрава Максим Степанов, сообщает ONLINE.UA.
Кроме того, он обратил внимание украинцев на то, что если эпидемическая ситуация в регионах, где ослабили карантин, в течение трех дней подряд будет сложной, региональная комиссия соберется вне очереди и отменит ослабление противоэпидемических мероприятий. По словам Максима Степанова, ослабление будут отменять, после детальной оценки текущей эпидемической ситуации в регионе.
Как известно, сейчас в нашей стране власти объявили адаптивный карантин, то есть ситуацию контролируют отдельно в каждом регионе, и усиливают или ослабляют меры безопасности в зависимости от количества больных в областях. Стоит обратить внимание на то, что в Украине от 5 июня Кабинет министров разрешил возобновить работу кафе и ресторанов в штатном режиме. То есть посетители смогут сидеть не только на летних площадках, но и внутри помещений.
Что важно понимать, новые изменения предусматривают:
разрешение лицам старше 60 лет не соблюдать условия самоизоляции;
ограничения деятельности учреждений оздоровления и отдыха детей;
разрешение на проведение аккредитации образовательных программ, по которым осуществляется подготовка соискателей высшего образования, в отдаленном (дистанционном режиме).
Ранее ONLINE.UA сообщал, что глава Минздрава Максим Степанов неожиданно обратился ко всем гражданам и заявил о давлении на министерство со стороны медиа и предшественников. Он также добавил, что сейчас информационное поле разделено на два лагеря.